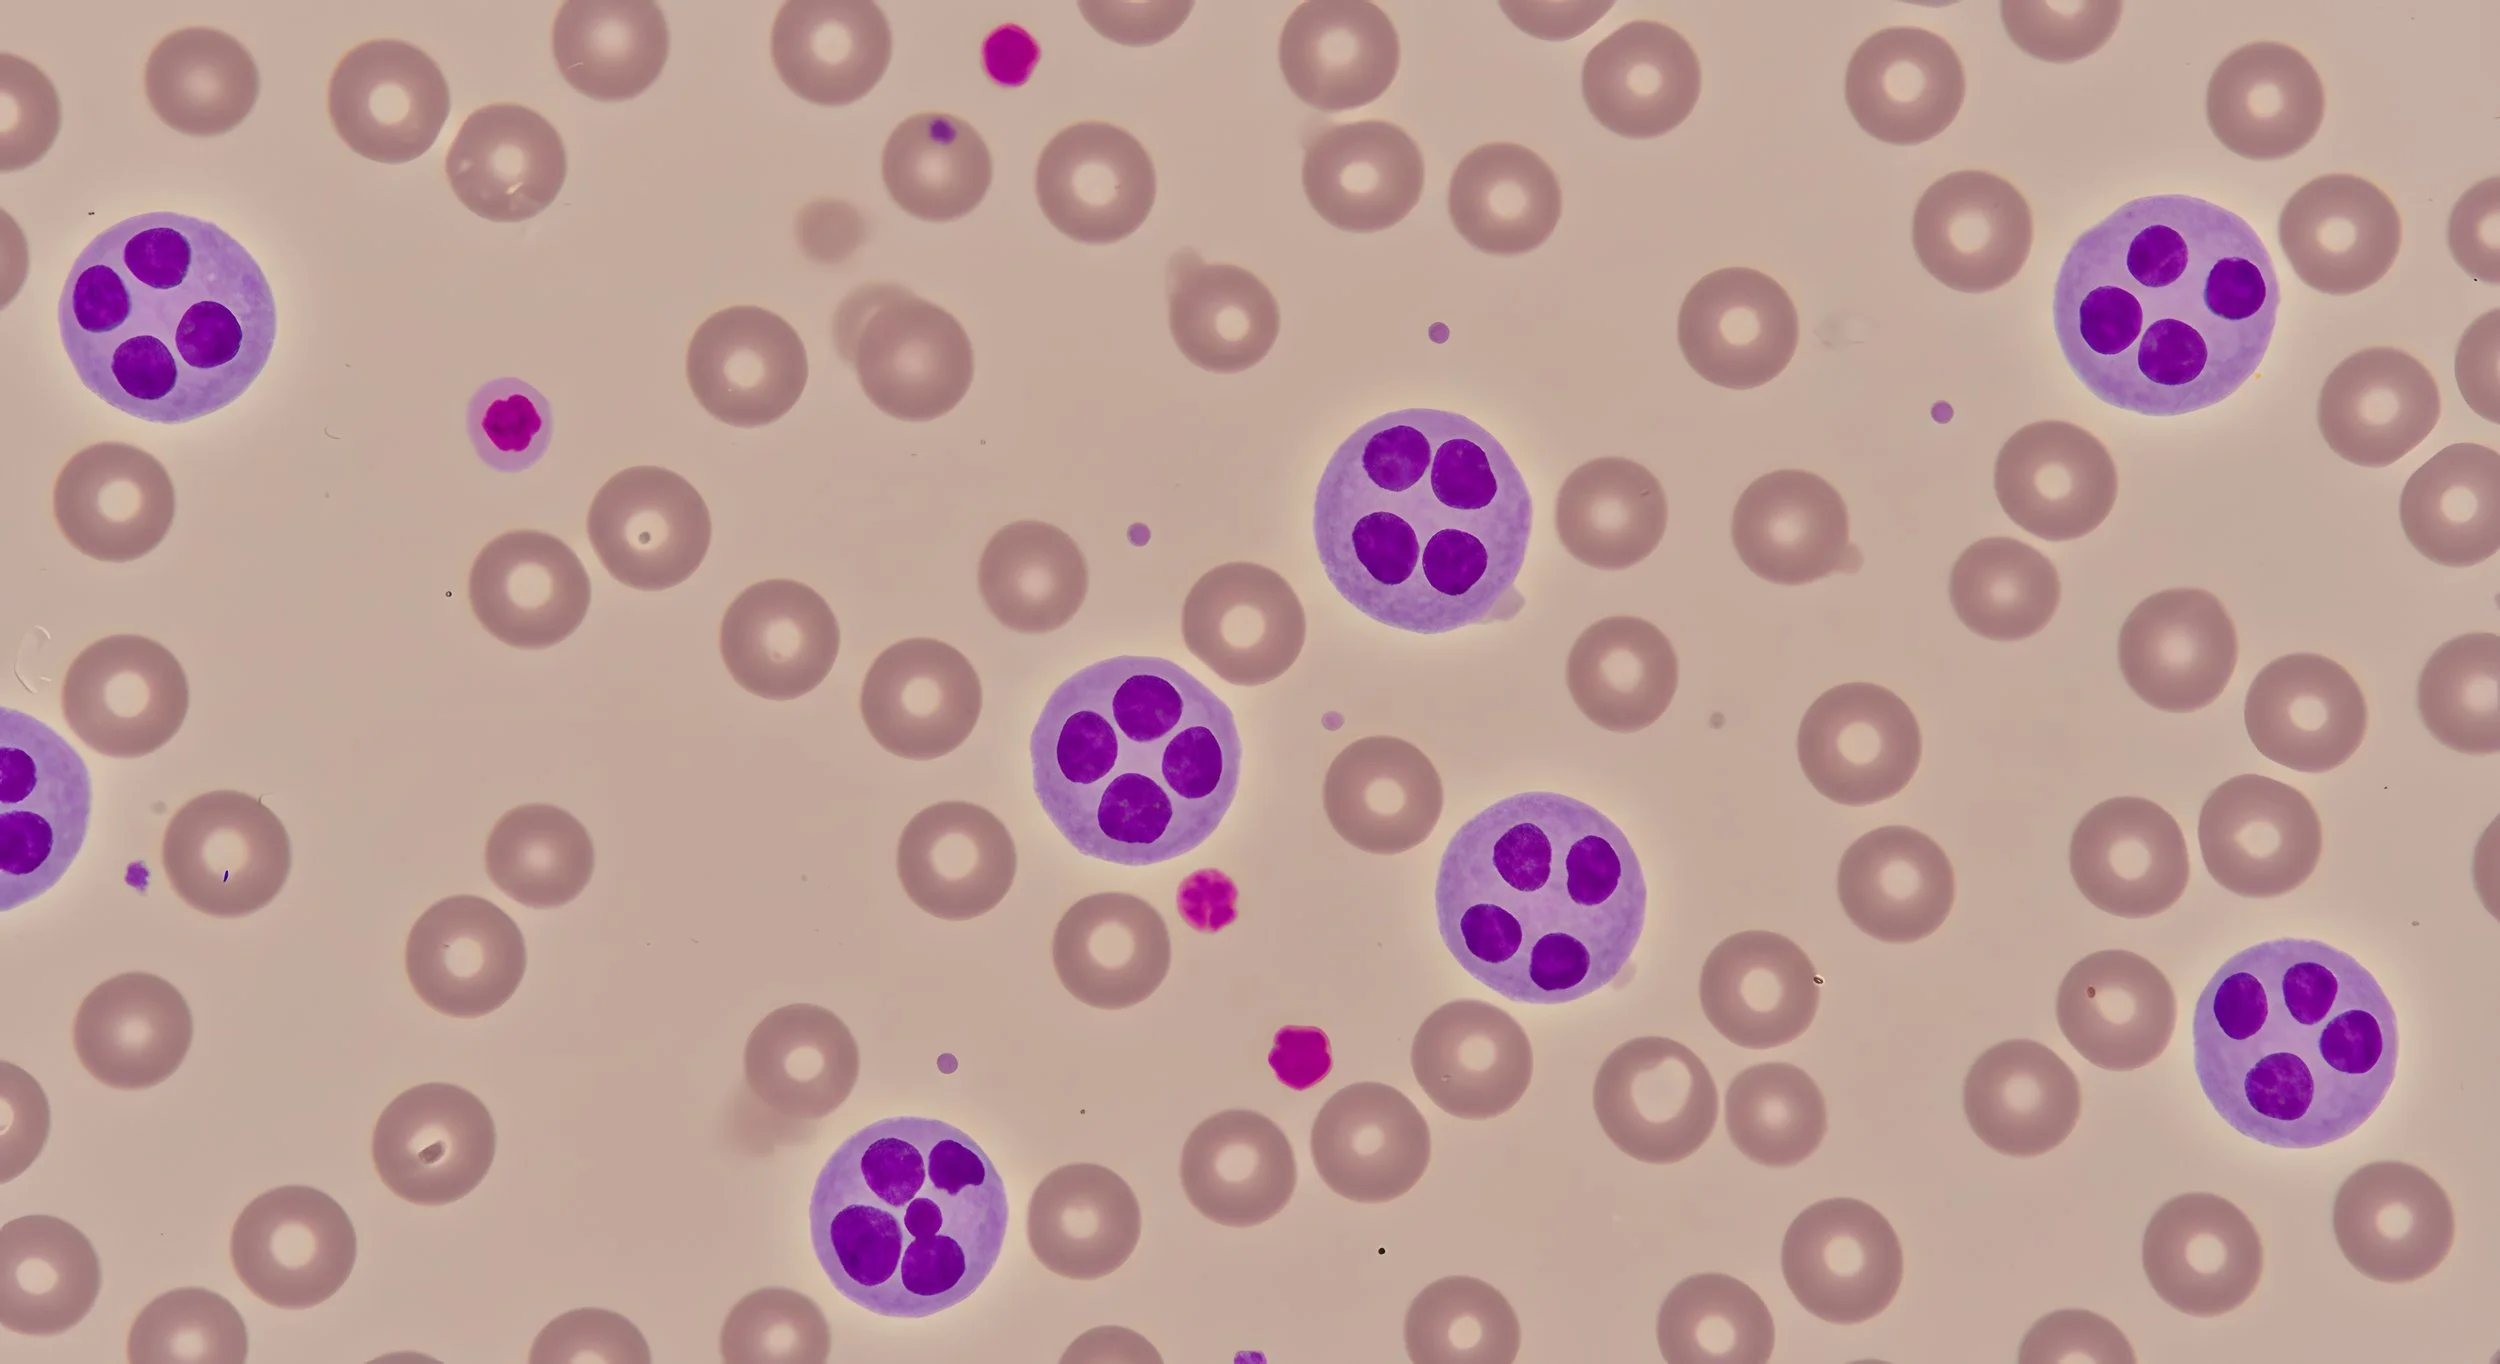

Meet Dr Lachie Hayes
Dr Lachie Hayes completed his medical degree at the University of Adelaide before undertaking six years of advanced training in clinical and laboratory haematology at The Royal Melbourne Hospital, Austin Hospital, Ballarat Base Hospital, and The Royal Children's and Royal Women's Hospitals.
For over 15 years, he has served the northern community, founding the Clinical Haematology Service at Northern Health in 2009, leading Cancer Services as the inaugural Medical Divisional Director in 2018, and supporting digital health advancements as the service’s first Chief Medical Informatics Officer.
As a general haematologist, medical executive, and health informatician, Lachie remains dedicated to community haematology, bringing expertise in digital health and patient-centred care. He has extensive experience across haematological conditions, with a special focus on non-malignant haematology, including anticoagulation, bleeding disorders, immuno-haematology, myeloproliferative disorders, and thrombosis. He has also led obstetric haematology at Mercy Hospital for Women for over a decade.
Lachie collaborates closely with sub-specialist haematologists and other medical experts at major hospitals, ensuring comprehensive patient care. A proud Brunswick resident, he enjoys connecting with friends and engaging with the local community.
Dr Lachie Hayes consults out of Melbourne Specialty Centre, 277 Lygon Street Brunswick, (directly across the road from Inner North Medical Clinic). Please note, you will need a referral to book with Dr Lachie.